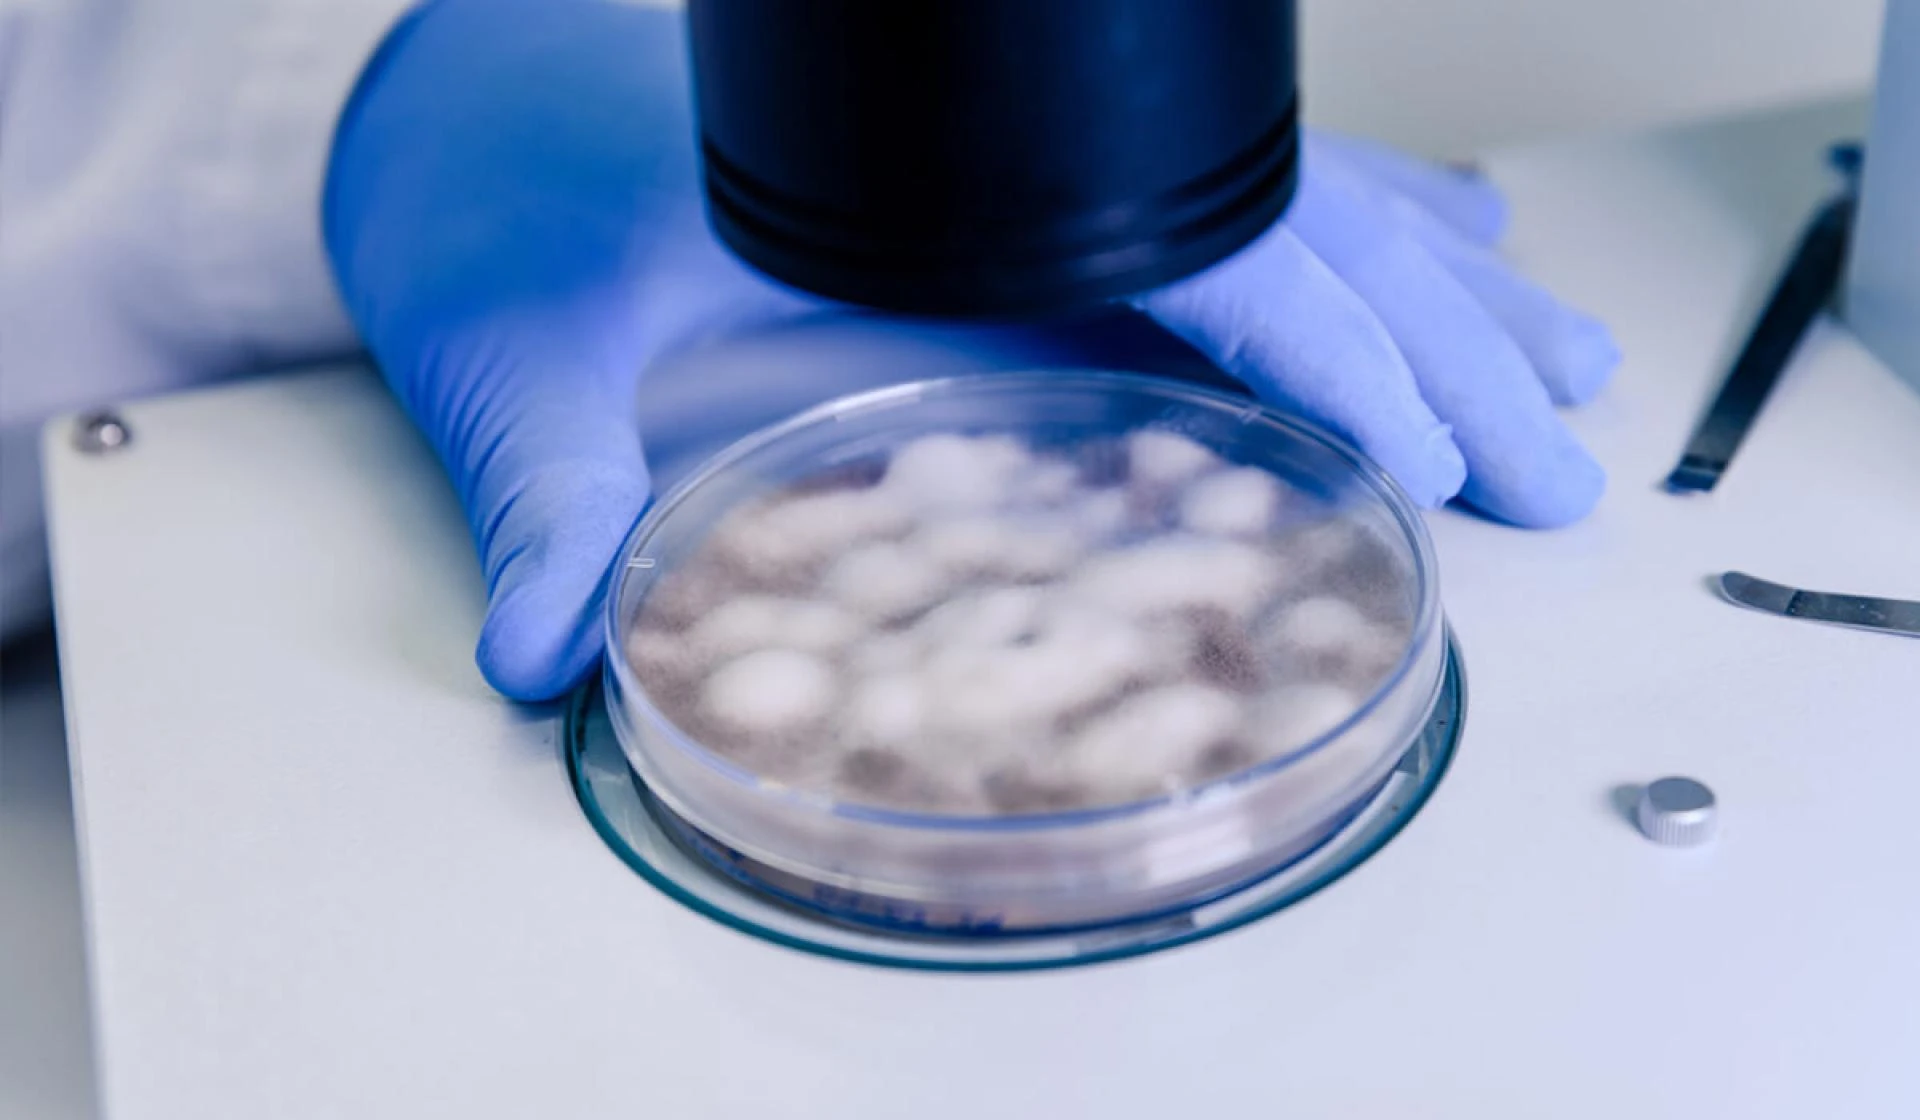

Health
What are the key considerations in designing drug candidates through medicinal chemistry services?
medicinal chemistry services, medicinal chemistry service, synthetic chemistry services